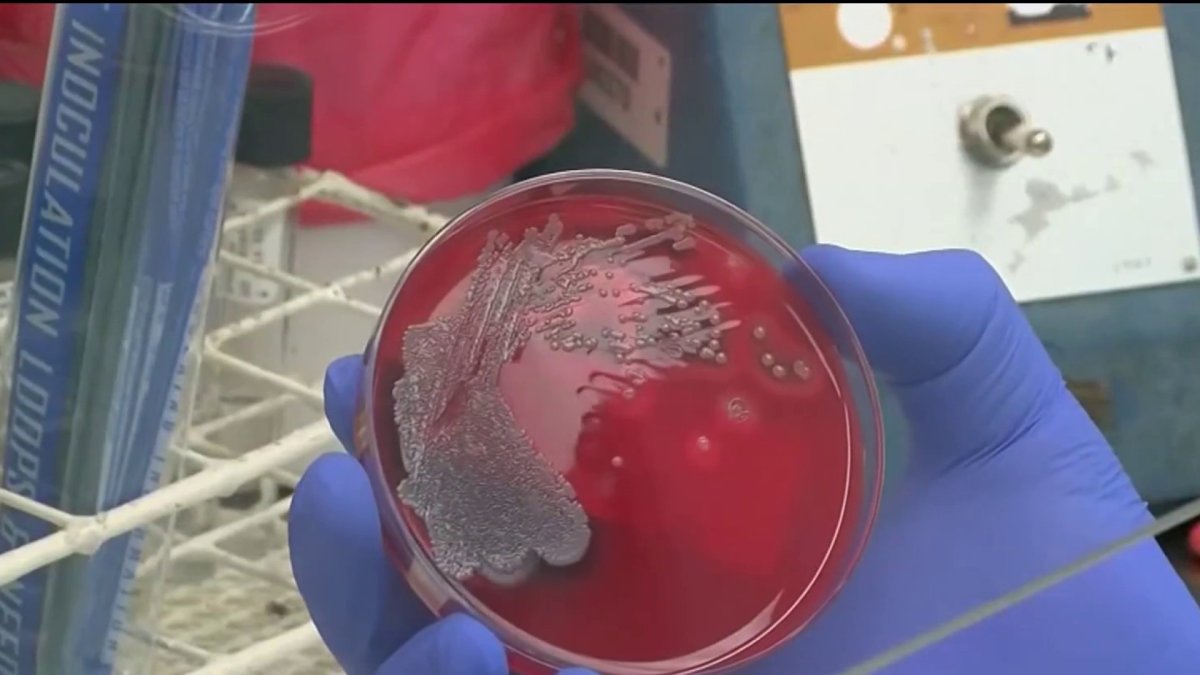
Potomac sewage pipe repairs delayed; tests show bacteria's spread

News
How dangerous is the bacteria spreading in the Potomac River? What to know about E. coli levels
 1+ hour, 30+ min ago (15+ words) Science 4 Everyone: How dangerous is the bacteria spreading in the Potomac River?NBC4 Washington...
1+ hour, 30+ min ago (15+ words) Science 4 Everyone: How dangerous is the bacteria spreading in the Potomac River?NBC4 Washington...
Multiple potential measles exposures in DC: Check sites and dates
 19+ hour, 14+ min ago (422+ words) DC Health said Saturday it was notified of multiple people with confirmed cases of measles who visited a variety of locations in the District. Officials did not specify exactly how many infected people there were. News4 has reached out to DC…...
19+ hour, 14+ min ago (422+ words) DC Health said Saturday it was notified of multiple people with confirmed cases of measles who visited a variety of locations in the District. Officials did not specify exactly how many infected people there were. News4 has reached out to DC…...
DC first responders train for rescues on the ice
 21+ hour, 18+ min ago (10+ words) DC first responders train for rescues on the ice'NBC4 Washington...
21+ hour, 18+ min ago (10+ words) DC first responders train for rescues on the ice'NBC4 Washington...
Ambulances diverted after burst pipe, flooding at GW Hospital
 1+ day, 12+ hour ago (308+ words) Flooding caused by the extreme cold prompted the Health Department at one of only two level one trauma centers in D.C. to divert ambulances this week, and staff members say conditions at the hospital already were extremely challenging. Edward Smith, executive…...
1+ day, 12+ hour ago (308+ words) Flooding caused by the extreme cold prompted the Health Department at one of only two level one trauma centers in D.C. to divert ambulances this week, and staff members say conditions at the hospital already were extremely challenging. Edward Smith, executive…...
Potomac sewage pipe repairs delayed; tests show bacteria's spread
1+ day, 18+ hour ago (10+ words) Potomac sewage pipe repairs delayed; tests show bacteria's spread'NBC4 Washington...
1+ day, 18+ hour ago (10+ words) Potomac sewage pipe repairs delayed; tests show bacteria's spread'NBC4 Washington...
Potomac sewage spill: Repairs to take weeks longer after large rocks found in pipe
 2+ day, 6+ hour ago (479+ words) The massive sewage spill into the Potomac River faces a new obstacle to repairs. News4s Jessica Albert reports. The blockage inside the collapsed sewer line that sent hundreds of millions of gallons of sewage into the Potomac River is worse than…...
2+ day, 6+ hour ago (479+ words) The massive sewage spill into the Potomac River faces a new obstacle to repairs. News4s Jessica Albert reports. The blockage inside the collapsed sewer line that sent hundreds of millions of gallons of sewage into the Potomac River is worse than…...
Pandemic disruptions to health care worsened cancer survival, study suggests
 2+ day, 22+ hour ago (507+ words) FILE " A radiologist uses a magnifying glass to check mammograms for breast cancer in Los Angeles, May 6, 2010. During the early years of the COVID-19 pandemic, experts worried that disruptions to cancer diagnosis and treatment would cost lives. A new study…...
2+ day, 22+ hour ago (507+ words) FILE " A radiologist uses a magnifying glass to check mammograms for breast cancer in Los Angeles, May 6, 2010. During the early years of the COVID-19 pandemic, experts worried that disruptions to cancer diagnosis and treatment would cost lives. A new study…...
Measles case reported in Northern Virginia adult. Check potential exposure sites and dates
 3+ day, 14+ hour ago (491+ words) Dr. Diego Hijano, a pediatric infectious disease expert from St. Jude Children's Research Hospital, answers your questions on how the MMR vaccine can protect your kids from the measles. Virginia health officials said Wednesday they have identified a measles case…...
3+ day, 14+ hour ago (491+ words) Dr. Diego Hijano, a pediatric infectious disease expert from St. Jude Children's Research Hospital, answers your questions on how the MMR vaccine can protect your kids from the measles. Virginia health officials said Wednesday they have identified a measles case…...
How cold could impact bacteria in Potomac after sewage spill
 3+ day, 14+ hour ago (363+ words) The cold weather could actually be keeping E. coli and other bacteria in the Potomac River from the raw sewage spill alive longer by slowing the natural cleansing process. Another factor that can keep the bacteria from breaking down naturally is…...
3+ day, 14+ hour ago (363+ words) The cold weather could actually be keeping E. coli and other bacteria in the Potomac River from the raw sewage spill alive longer by slowing the natural cleansing process. Another factor that can keep the bacteria from breaking down naturally is…...
High E. coli levels detected in Potomac River after massive sewage spill
 1+ week, 4+ day ago (13+ words) High E. coli levels detected in Potomac River after massive sewage spill'nbcwashington.com...
1+ week, 4+ day ago (13+ words) High E. coli levels detected in Potomac River after massive sewage spill'nbcwashington.com...